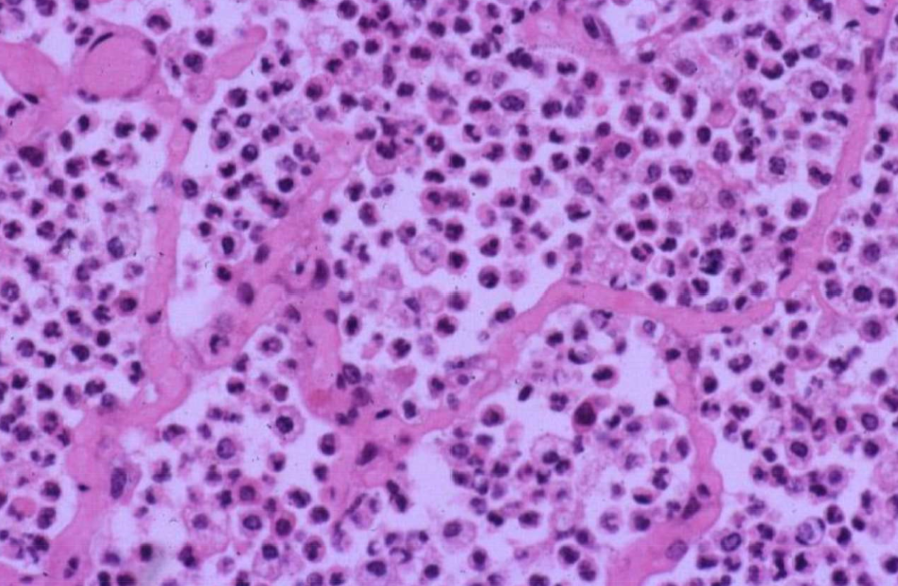

Extracellular Matrix
The structural Framework in which cells organize, move and interact
Provides sites for cell adhesion and a conduit for exchange of cell nutrients and wastes
Promerties of the ECM
- It dictates tissue architecture and organization
- has specific features for each tissue/organ
- bone, liver, brain, lung, intestine, skin
- has specific features for each tissue/organ
- It regulates or modifies many cell activities
- I serves as a reservoir of growth factors and bioactive molecules
- It is constantly remodeling and changing.
Processes influenced by ECM
- The ECM plays a major role in:
- Embryogenesis
- Fibrosis
- Would healing
- Cell behavior
- morphogenesis, differentiation, adhesion, migration, apoptosis
- Carcinogenesis
- Tumor invasion and metastasis
Componenets of the ECM
- The “matrisome” consists of over 300 different proteins
- These components fall into 3 categories:
- Structural
- Absorptive
- Adhesive
ECM:
Structural
- Structural components of the ECM build the framework for cells to exist upon and within
- Structural components include:
- Collagen
- many different types exist for different situations
- Elastin
- Most prominent where elasticity is needed
- Collagen
Collagen Types
There are at least 28 different types of collagen
- structural collagen of most tissues
- Major component of cartilage
- Basement membranes
Collagen Disorders:
Marfan Syndrome
- A mutation in the gene encoding fibrillin-1
- Fibrillin-1 is a structural component of microfibrils and regulates formation of elastic fibers
- Elevated levels of TGF-beta also occur and contribute to the disease
- Features include, tall, slender build, disproportionally long fingers and toes, lens dislocation, and aortic weakening
Dermatosporaxis
Ehler-Danlos Syndrome
- A group of inherited connective tissye disorders characterized by defective collagen synthesis
- Dermatosporaxis is one varient of this condition

ECM:
Absorptive
- These absorb water and other soluble substances which bath surrounding cells
- Major absorptive components:
- Glycosaminoglycans (GAGs)
- these are polysaccharides consisting of 4 main groups:
- hyaluronic Acid
- Heparan sulfate
- Chondroitin/dermatan sulfate
- Keratan sulfate
- Proteoglycans
- these are proteins with GAG side-chains
- these are polysaccharides consisting of 4 main groups:
- Glycosaminoglycans (GAGs)
- These exert important osmotic pressures to help maintain water balance
Proteoglycans and Edema
- Edema is the excessive accumulation of fluid in the extracellular matrix or within body cavities
- Edema has various causes, one of which is a change in concentrations or properties of absorptive molecules in the ECM
ECM:
Adhesive
- Sites of attachment for structural ECM components and cells
- Adhesive components:
- Fibronectin
- Laminin
- Many others
- These mediate interactions of fixed or mobile cells with the ECM
Fibronectin and Wound Healing
- A glycoprotein that attaches to integrins as well as extracellular matrix proteins such as collagen, fibrin, and proteoglycans
- Fibronectin is critical for wound healing
- provieds binding sites for macrophages, endothelium, and fibroblasts during tissue repair and healing
- Contributes to formation of the granulation tissue matrus
- Can influence cell function and protein expression

Fibronectin
- Other roles of fibronectin include:
- Cell migration and differentiation during embryogenesis
- fibronectin deficiency can lead to embryonic death, or defects in neural and vascular development
- Hemostasis
- in conjunction with fibrin
- Carcinogenesis
- May promote tumor growth and survival
- Cell migration and differentiation during embryogenesis
Injury to the ECM
- General patterns of injury
- increased destruction
- decreased production
- Excessive production
- Depostition of abnormal substances
Increased Destruction of ECM
- The ECM exists in a dynamic balance of production and degredation
- fibroblasts produce collagen
- Matrix metalloproteinases among other enzymes degreade collagen
- MMP 1 = collagenase
- Decreased ECM occurs when the balance of degredation exceeds production
- Causes include:
- Excessive MMP activity:
- this has been associated with various conditions, including vascular disease, neoplasia, skin and muschuloskeletal disorders
- Inflammation:
- Lysosomal enzymes are released into the ECM
- Excessive amounts of MMP
- collagenases and elastases
- Excessive amounts of MMP
- Oxygen free radivals and cytokines damage ECM
- Lysosomal enzymes are released into the ECM
- Immunologic reactions
- immunologic activation of inflammatory responses
- Excessive MMP activity:
- Morphology:
- Gross:
- Corresponds to the different types of necrosis
- Histologic:
- Collagen is swollen, uniformly eosinophilic fragmented, or absent
- Inflammation is usually present
- Gross:
Decreased Production of ECM
- Causes:
- occur as inherited diseases of collagen formation
- collagen dysplasia
- Nutritional deficiencies can influence ECM production
- Vitamin C is a critical element for collagen formation and maintenance
- occur as inherited diseases of collagen formation
- Morphology:
- Gross:
- Skin is very distensible and fragile
- Tears in the skin
- Histologic:
- No abnormalities in come cases
- Collagen of vairable size and shape
- Abnormal collagen organization
- Gross:

Excessive Production of ECM
- This is predominately associated with healing in irreversibly damaged tissue
- fibrosis and scar formation
- Excessive fibrosis can interfere with tissue and organ function
- Fibrosis can have major detrimental effects when located in critical tissues
- heart, liver, kidneys, etc.
- Fibrosis can have major detrimental effects when located in critical tissues
- Causes:
- Upregulation of collagen-producing cells
- predominately firbroblasts
- Shift in ECM homeostatsis or metabolic problem
- Any stimulus resulting in irreversibly damaged tissue
- Tissue is replaced by collagen as part of healing
- fibrosis and scar formation
- Tissue is replaced by collagen as part of healing
- Upregulation of collagen-producing cells
- Morphology:
- Gross:
- Dense, white fibrous tissue replacing normal tissue
- abnormal relationships between tissues and organs
- excessive fibrosis can interfere with organ function
- Histologic:
- Densely packed collagen
- Initially increased fibroblasts
- Later mainly collage with a few firbroblasts
- Gross:

Depostition of Substances in ECM
- Abnormal substances can be deposited in both normal and abnormal ECM
- Common substances depostied:
- Amyloid
- Calcium
- Iron
- Excessive collagen
ECM depostition:
Amyloid
- Chymically diverse protein that has a B-pleated sheet confirmation
- Composition
- 95% fibrillar proteins
- 5% other proteins
- serum amyloid P protein
- Proteoglycans
- Glycosaminoglycans
- Composition
- Over 30 biochemically distinct forms of disease-associated amyloid have been described
- Most common forms:
- Amyloid light chain (AL) protein
- immunoglobulin light chains
- Amyloid-associated (AA) protein
- derived from serum AA produced by the liver
- AB amyloid
- fragment derived form amyloid precursor protein (APP)
- Amyloid light chain (AL) protein
- Most common forms:
- Cause:
- Due to abnormal folding of amyloid proteins
- deposition is usually due to :
- Normal protein that have a tendency to misfold when produced in excess
- Abnormal proteins formed due to mutations
- Misfolded amyloid can’t be degraded and accumulates extracellularly in the ECM
- May be a defect in normal degradative processes
- May be an abnormal protein that can’t be degraded
- deposition is usually due to :
- Due to abnormal folding of amyloid proteins
- Morphology:
- Gross:
- Deposition can occur either locally or systemically
- Affected organs are enlarged, firm, and discolored
- Detectable with lugol’s iodine and sulfuric acid
- Histologic:
- Eosinophilic, acellular, amorphous, fibrillar extracellular protein that displaces normal tissue components
- some types of amyloid can be intracellular as well
- Stains with congo red dye
- produces apple-green fluorescence with polarized light
- Eosinophilic, acellular, amorphous, fibrillar extracellular protein that displaces normal tissue components
- Gross:

ECM Deposition:
Amyloid:
Syndromes
- Characterized by amyloid deposition have been described, including:
- Primary amyloidosis
- Secondary (Reactive) amyloidosis
- Amyloidosis of aging
- Endocrine amyloidosis
- Familial Amyloidosis
ECM deposition:
Amyloid:
Primary amyloidosis
- This is usually associated with immunological dyshomeostasis and deposition of AL protein
- It is most commonly associated with plasma cell neoplasia
- neoplastic cells produce excessive amounts of immunoglobulin and immunoglobulin light chains

ECM Deposition:
Amyloid:
Secondary Amyloidosis
- Usually associated with chronic inflammation and tissue destruction with deposition of AA protein
- Cytokines and cell damage associated with chronic inflammation increases production of SAA
- Abnormal breakdown of SAA or sturctural abnormalities in the SAA results in deposition in the ECM
- Most common form in domestic animals

ECM Deposition:
Amyloid:
Amyloidosis of aging
- Deposition of AB amyloid can occur in the brain of old dogs
- this type is characteristic of Alzheimer’s disease of humans
- Deposition less often occurs in heart, GI tract, and lungs of old dogs
ECM Deposition:
Amyloid:
Endocrine Amyloidosis
- Amyloid is deposited in the pancrease (islets) of cat
- protein is derived from a normal product of pancreatic islet B cells
- Amyloid deposition can result in Type 1 diabetes mellitus
- Also occurs in some non-human primates and humans






